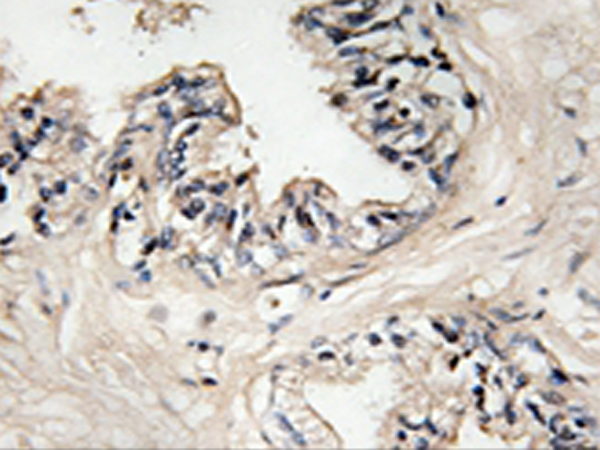

中文名稱: 兔抗MRPS36多克隆抗體
英文名稱: Anti-MRPS36 rabbit polyclonal antibody
別 名: DC47; MRP-S36
抗 原: MRPS36
儲(chǔ) 存: 冷凍(-20℃) 避光
宿 主: Rabbit
反應(yīng)種屬: Human
相關(guān)類別: 一抗
標(biāo) 記 物: Unconjugate
克隆類型: Unconjugate
技術(shù)規(guī)格
|
Background: |
Another difference between mammalian mitoribosomes and prokaryotic ribosomes is that the latter contain a 5S rRNA. Among different species, the proteins comprising the mitoribosome differ greatly in sequence, and sometimes in biochemical properties, which prevents easy recognition by sequence homology. This gene encodes a 28S subunit protein. Pseudogenes corresponding to this gene are found on chromosomes 3p, 4q, 8p, 11q, 12q, and 20p. |
|
Applications: |
WB, IHC |
|
Name of antibody: |
MRPS36 |
|
Immunogen: |
Synthesized peptide derived from internal of human MRPS36. |
|
Full name: |
mitochondrial ribosomal protein S36 |
|
Synonyms: |
DC47; MRP-S36 |
|
SwissProt: |
P82909 |
|
IHC positive control: |
Human breast carcinoma tissue |
|
IHC Recommend dilution: |
50-100 |
|
WB Predicted band size: |
11 kDa |
|
WB Positive control: |
HepG2 cells lysate |
|
WB Recommended dilution: |
500-3000 |

購物車
幫助
021-54845833/15800441009
